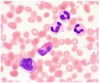
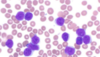

IBI Flashcards
(143 cards)
Beskriv den farmakologiska mekanismen för hur behandling med anti-histamin kan minska Olgas klåda
Antihistamin binder H1-receptorer i vävnaden och hämmar därmed vasodilatation och påverkan på nervändar (klåda).
Vilken är den viktigaste riskfaktorn för allergi?
Hereditet/ärftlighet
Olga, litet barn (4 mån) med atopiskt Eksem, vilka två allergen vill du testa om hon har antikroppar mot?
Födoämnesallergi vanlig orsak till eksem hos spädbarn – mjölk/ägg (mkt vanligt)
Viktigt att fråga innan ett pricktest utförs?
Om patienten tagit anti-histamin de senaste dagarna
Mamman till barn med atopiskt eksem har slutat dricka mjölk men äter fortsatt ägg vilket också barnet har fått små bitar av. Symptomen av det atopiska eksemet har försvunnit och nu visar proverna detta. Vad tyder det på tillsammans med anamnes?

Sensibilisering innebär förekomst av IgE mot ett allergen, för att ha en IgE-medierad allergi krävs förutom specifikt IgE även symtom vid exponering för allergenet. Olga är sensibiliserad mot mjölk och ägg men har enbart en mjölkallergi
Ange två olika organsystem som ofta drabbas vid en anafylaktisk reaktion utöver cirkulationssystemet
Luftvägar, hud och magtarmkanal
Olga (1 år) får en anafylaktisk chock. Beskriv varför det är viktigt att hon snabbt får adrenalin? Koppla svaret till adrenalinets farmakologiska mekanismer
Adrenalin binder till
- alfa-1 receptorer i kärl vilket ger en vasokonstriktion (minskar vätskeuträde och höjer blodtryck)
- beta-1 receptorer i hjärtat vilket ökar kontraktionskraften (blodtryckshöjande)
- beta-2 receptorer i luftvägarna vilket leder till en bronkodilatation.
Sammantaget häver adrenalin astma/anafylaxi
Vad händer mekanistiskt vid en anafylaktisk chock?
Antigen/allergen korsbinder IgE-molekyler som sitter bundna till Fc-receptorer på mastceller ivävnaden. Mastceller innehåller granulae med histamin och andra proinflammatoriska substanser som frisätts när Fc-receptorer aktiveras
Beskriv mekanistiskt hur mastcellsaktivering leder till att granulocyter och T-celler lämnar cirkulationen och träder ut i vävnaden.
Proinflammatoriska cytokiner och andra inflammatoriska mediatorer (histamin ex) som bildas och frisätts av mastceller, leder till vasodilatation, uppreglering av E-selectin och ICAM på endotelet vilket i kombination med att det produceras kemokiner lokalt leder till ett utträde av leukocyter i vävnaden.
Beskriv de immunologiska mekanismerna på cellulär nivå för hur den kroniska allergiska inflammationen i Olgas luftvägar kan ge upphov till vävnadsskada
Aktivering av eosinofiler, via IL-5 från Th2-celler ger skador på mukosa och epitel genom frisättning av leukotriener och eosinofilspecifika cytotoxiska proteiner såsom MBP, EPO, ECP och EDN
Figuren visar en schematisk bild av en IgG-molekyl t ex omalizumab. Ange och beskriv antikroppens funktionella delar samt markera dessa i figuren

- Antigenbindande del (variabel del) av lätt och tung kedja
- FAB – fragment antigen binding
- Tung kedja är konstant i botten (FC-delen (FLAGGA)
- Fem olika isotyper: IgA, IgD, IgE, IgG och IgM
- binder till Fc-receptorer (på ex fagocyt som då hittar patogenet eftersom antikroppen sitter där) eller också komplement
- FC-delen avgör effektorfunktionen ex opsoniserande, komplementfixerande och neutraliserande

Förutsatt att det är kattallergi som främst bidrar till Olgas astma, hur kommer sannolikt resultatet av CD-sens för kattallergen förändras i Olgas fall jämfört med utgångsvärdet, om hon påbörjar behandling med omalizumab (monoklonal antikropp)? Motivera ditt svar.
Basofiler aktiveras genom korsbindning av IgE. Behandling med anti-IgE leder till mindre mängd IgE i cirkulationen, mindre IgE på basofiler, aktiveringen av basofiler kommer minska och därmed CD-sens värdet
Patient med feber, frossa, diarréer sedan tre dygn, diarréer tre ggr/h. Skriv ner minst 3 viktiga epidemiologiska frågor som Du vill ställa till patienten utifrån det beskrivna fallet.
- Är det någon annan i omgivningen som är sjuk?
- Har Du varit utomlands? Antibiotikaanvändning nyligen?
- Har Du ätit något speciellt (som ingen annan i omgivningen har)?
- Har ni kommunalt vatten eller egen grävd brunn?
- Har Du lagat mat till någon annan sedan Du blev sjuk?
- Vilket yrke har Du? Riskyrke?
Patient med feber, frossa, diarréer sedan tre dygn, diarréer tre ggr/h. Du misstänker att fokus för febern sitter i mag-tarmkanalen. Vilken etiologisk diagnostik ordinerar Du (man hann inte göra dylik på Akutmottagningen)?
- Feber/frossa – blododling x2
- Diarréer – fecesodling (PCR screening + odling)
Patient med feber, frossa, diarréer sedan tre dygn, diarréer tre ggr/h. Ange ett virus respektive två olika bakterier som skulle kunna orsaka Henriks symtom med feber och diarré
Novovirus, adenovirus rotavirus, salmonella, Shigella Yersinia och campylobacter
Virus som orsakar gastroenterit är ofta mycket stabila i miljö och kan förbli infektiösa i vatten och mat (relativt kall) under lång tid. Vilka egenskaper hos virusen och deras struktur kan förklara detta?
Detta är virus utan fetthölje, troligen bara med ikosahedral struktur på kapsiden vilket gör den stabil och tålig mot varierenade miljöer (kom ihåg, de ska ta sig igenom den sura magmiljön)
Patient med feber, frossa, diarréer sedan tre dygn, diarréer tre ggr/h. Insjuknade tre dygn efter hämtmat. Utifrån Henriks anamnes, vilka faktorer tycker du ytterligare talar för en bakterieorsakad snarare än en virusorsakad infektion.
Misstanke om relativt lång inkubationstid samt förhållandevis långdragna symtom (mer än 2 dygn), hög feber och avsaknad av/sparsamt med kräkningar.
Ange två fördelar och två nackdelar med diagnostik av tarmpatogener med realtids-PCR jämfört med traditionell mikrobiologisk diagnostik med ELISA, serologi och odling?
Fördelar
- Mycket känslig och specifik jämfört med ELISA. Möjliggör kvantifiering.
- Möjliggör multiplex, screena flera olika virus samtidigt i samma prover (genom använda prober med olika fluroforer ”färger”).
- Direkt metod, påvisar agens direkt (jmf med serologi), dessutom tar det ju tid för ak att bildas
Nackdelar
- Relativt dyr och ”svår”.
- Mer avancerad utrustning
- Känslig för kontamination.
- Känslig för mutation i virusgenomet.
- Ingen resistensbestämning av bakterier
Ange tre principiellt olika försvarsmekanismer som normalt skyddar mot kolonisering av salmonella och andra tarmpatogener i magtarm-kanalen.
- Lågt pH i magsäcken
- Peristaltik
- Mucus
- Normalflora
- Sekretoriskt IgA
- Avstötning av epitelceller
Beskriv i detalj mekanismerna för hur en B-cell börjar producera antikroppar av isotypen IgA mot ett antigen.
- En DC i lamina propria kommer i kontakt med luminalt antigen (t.ex. via utskott som den sticker upp mellan epitelcellerna) och presenterar detta på MHC klass II för en Thjälparcell (TCR till MHC-II, costimulering med dendritens B7 till T-cellens CD28, T-cellens CD4 stabiliserar också MHC-II)
- Samma antigen har också tagits upp av en B-cell via BCR. B-cellen presenterar antigenet också på MHC klass II för Thjälparcellen (T-cellen Co-stimulerar B-cellens CD40 med CD40L). Miljön i tarmen, ffa styrd av de cytokiner DC och Th producerar (t.ex. TGF-b), men också vitamin A och frånvaro av proinflammatoriska cytokin leder till att B-cellen switchar och producerar antikroppar av IgA-klass.
Ange en så kallad pattern recognition receptor (PRR) som uttrycks i tarmepitelceller och som aktiveras av bakterier/bakteriekomponenter i cytoplasma
- NOD-like receptor (NLR)/NOD-1/-2/
- Toll-like receptor TLR
Beskriv hur aktiveringen av NOD1/2 i epitelcellens cytoplasma bidrar till att Henriks medfödda immunsystem kan begränsa tarminfektionen till slemhinnan. Förklara på cellulär och molekylär nivå
NOD-aktivering leder till NFKb aktivering vilket i sin tur leder till ett uttryck av proinflammatoriska cytokiner, kemokiner och andra mediatorer så som antimikrobiella defensiner. Kemokiner leder till rekrytering och aktivering av monocyter, dendritiska celler samt neutrofila granulocyter. Neutrofila granulocyter begränsar infektionens utbredning.
Varför är handhygienen viktig vid salmonellainfektion?
Salmonella är en fecal-oral smitta
Du tänker att Linda sannolikt drabbats av pyelonefrit. Det är ett allvarligt tillstånd där bakterier kan träda ut i blodbanan och orsaka sepsis. I amnesen står det att hon haft frossa och är dunköm. I kliniskt status noterar du Allmäntillstånd: RLS 1, temp 39,7 C Andningsfrekvens: 24/min, syrgasmättnad: 95% Cor: regelbunden rytm, 112 slag/min Blodtryck: 100/75 Pulm: auskulteras ua, inga biljud, Buk: mjuk, viss ömhet över urinblåsan samt tydlig ömhet över höger njurlogeA2. Ange två kliniska fynd eller anamnestiska uppgifter, utöver feber, som talar för att Linda har sepsis.
Frossa, snabb andningsfrekvens, lågt blodtryck, takykardi